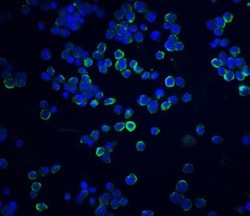
XBP1 Antibody - BSA Free, Novus Biologicals 0.025 mg | Buy Online | Novus Biologicals | Fisher Scientific

missing translation for 'onlineSavingsMsg'
Learn More
Learn More
Descripción
XBP1 Polyclonal specifically detects XBP1 in Human, Mouse, Rat samples. It is validated for Western Blot, ELISA, Immunohistochemistry, Immunocytochemistry/Immunofluorescence, Immunohistochemistry-Paraffin.

Especificaciones
Especificaciones
| Antígeno | XBP1 |
| Aplicaciones | Western Blot, ELISA, Immunohistochemistry, Immunocytochemistry, Immunofluorescence, Immunohistochemistry (Paraffin) |
| Clasificación | Polyclonal |
| Concentración | 1 mg/mL |
| Conjugado | Unconjugated |
| Dilución | Western Blot 0.5-2 μg/mL, ELISA 1:100-1:2000, Immunohistochemistry 5 μg/mL, Immunocytochemistry/Immunofluorescence, Immunohistochemistry-Paraffin 5 μg/mL, Immunofluorescence 20 μg/mL |
| Formulación | PBS with 0.02% Sodium Azide |
| N.º de referencia del gen | BAB82982 |
| Alias de gen | TREB5, X-box binding protein 1, X-box-binding protein 1, XBP-1, XBP2Tax-responsive element-binding protein 5 |
| Símbolos de los genes | XBP1 |
| Mostrar más |
For Research Use Only
Título del producto
Al hacer clic en Enviar, acepta que Fisher Scientific se ponga en contacto con usted en relación con los comentarios que ha proporcionado en este formulario. No compartiremos su información para ningún otro fin. Toda la información de contacto proporcionada se mantendrá de acuerdo con nuestra Política de Privacidad. Política de privacidad.
¿Detecta una oportunidad de mejora?